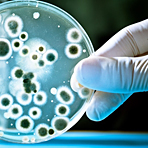

EU-Kommission: Zunahme resistenter Keime sehr bedrohlich |
Die EU-Kommission warnt eindringlich vor der Zunahme gefährlicher Erreger, gegen die gleich mehrere Antibiotika nicht mehr wirken. «Angesichts von 25.000 Toten pro Jahr und 1,5 Milliarden Euro an Gesundheitskosten und Produktionseinbußen in der EU, brauchen wir eine robuste Informationskampagne mehr denn je», erklärte Gesundheitskommissar Vytenis Andriukaitis heute. Anlass war der zehnte europäische Antibiotika-Aktionstag.
Da Keime zunehmend sogar gegen Reserve-Antibiotika resistent seien, drohe eine Zukunft, in der große Operationen oder Organverpflanzungen nicht mehr möglich sein könnten. Im Jahr 2050 könnte dies alle drei Sekunden einen Menschen töten und damit mehr als Krebs, hieß es weiter. Diese «unvorstellbare Zukunft» müsse abgewendet werden.
Wie das Europäische Präventionszentrum ECDC mitteilte, nahmen sogenannte Multiresistenzen zwischen 2013 und 2016 unter anderem bei dem weit verbreiteten Darmkeim Escherichia coli zu. Ähnliche Trends melden die Wissenschaftler für Acinetobacter-Stämme in Süd- und Südosteuropa und im Baltikum. Die Entwicklung sei besorgniserregend, weil es für Patienten, die mit solchen Keimen infiziert sind, kaum noch Behandlungsoptionen gebe.
Gleichwohl sehen die Wissenschaftler auch Lichtblicke. Bei dem weit verbreiteten Bakterium Klebsiella pneumoniae, das Atem- und Harnwegserkrankungen auslösen kann, stabilisiere sich die Lage. Und bei Staphylococcus aureus, der ebenfalls für schwerwiegende Krankheiten bis hin zu Lungenentzündung und Blutvergiftung verantwortlich ist, sei der Anteil der multiresistenten Keime zwischen 2013 und 2016 weiter zurückgegangen. Man sehe inzwischen kleine Fortschritte, erklärte ECDC-Direktorin Andrea Ammon.
Mehr zum Thema Antibiotika
15.11.2017 l dpa
Foto: Fotolia/Alexander Raths